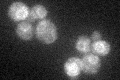
YCR017C
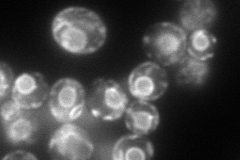
YCR017C
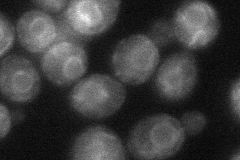
YCR017C
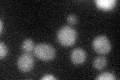
YCR017C
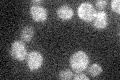
YCR017C

View description
Putative sensor/transporter protein involved in cell wall biogenesis; contains 14-16 transmembrane segments and several putative glycosylation and phosphorylation sites; null mutation is synthetically lethal with pkc1 deletion
Localization:
Intensity:
Fold change:
Significance:
-
C’ GFP library in SD
ER29.14 -
N' NOP1pr-GFP in SD
ER158.388 -
N' TEF2pr-mCherry in SD

ER245.714 -
N' NATIVEpr-GFP in SD

below threshold20.7015 -
N' TEF2pr-VC and Cyto-VN in SD
ER45.8196 -
C’ GFP library in SD+DTT
ER18.430.63Yes -
C’ GFP library in SD+H2O2

ER25.050.85No -
C’ GFP library in Starvation Media
ER26.820.92No -
C’ GFP library on the background of Pup2-DaMP

ER -
C’ GFP library on the background of CCT mutant

ER25.47730.874031No
